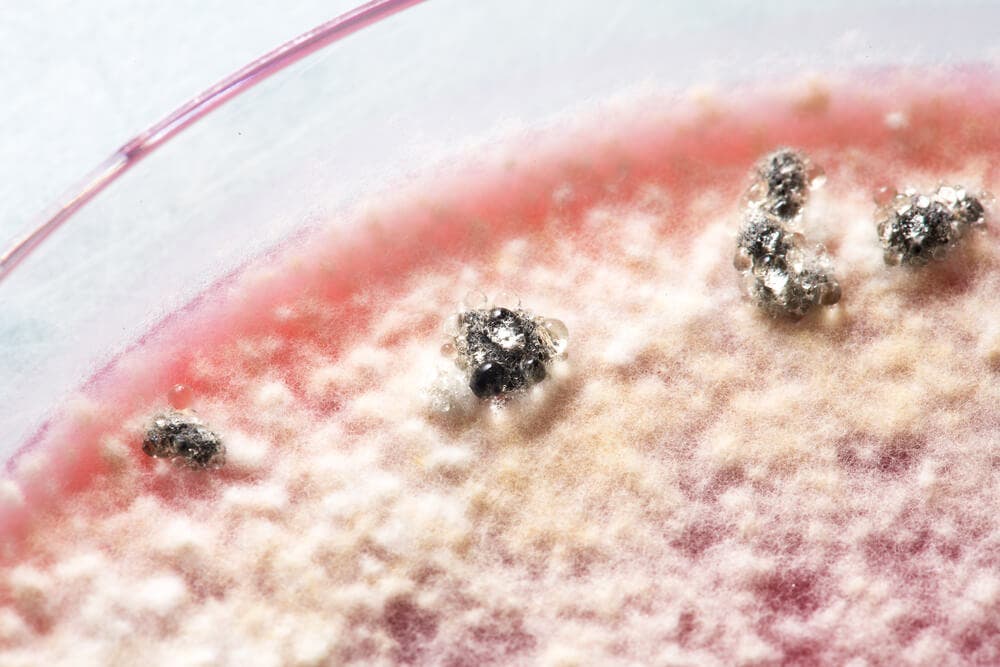
Some figure

¿Por qué se generan cepas resistentes a antibióticos?


Revisado y aprobado por la farmacéutica Lourdes Martínez
Un gran problema que presenta la medicina actual es la presencia de cepas resistentes a antibióticos. Estas cepas resistentes a antibióticos pueden aparecer por diversos motivos, pero está claro que el más importante es la automedicación por parte del paciente y el abuso de estos fármacos.
¿Qué es un antibiótico?
Debemos tener claros ciertos términos para entender por qué se generan cepas resistentes a antibióticos. Estos fármacos etiológicamente vienen del griego anti ”contra” y bios ”vida”.
Se pueden difinir como una sustancia química producida por un ser vivo o fabricada artificialmente por humanos que capaz de paralizar el desarrollo de ciertos microorganismos patógenos o de causar la muerte de ellos directamente.
En el primero de los casos estaremos hablando de antibióticos bacteriostáticos, ya que solo intervienen en el desarrollo del microorganismo. Sin embargo, en el segundo caso se denominan bactericidas, ya que dan la muerte al patógeno.
Si lo explicamos de una manera más sencilla, podríamos decir que los antibióticos son sustancias que matan a bacterias o hacen que éstas dejen de crecer. Es importante tener claro que los antibióticos solo afectan a bacterias, no a los virus.
Ver también: ¿Qué son los antibióticos?
¿Cómo actúan los antibióticos?
Una de las propiedades más importantes de estos fármacos es la toxicidad selectiva que presentan. La acción que ejercen sobre los microorganismos invasores es superior a la toxicidad frente a los huéspedes, es decir, los animales o personas que estén infectados.
Los antibióticos pueden actuar sobre el organismo patógeno de diferentes maneras, dependiendo que estructura va a alterar. Por un lado pueden inhibir la síntesis de la pared celular de las células. La pared celular es una estructura rígida característica de las bacterias y proporciona protección a las bacterias
Al impedir que esta se forme, las células se rompen y mueren, ya que es una estructura imprescindible para la vida del microorganismo.
Otra opción es la de actuar sobre las membranas celulares, alterando la capacidad de estas para actuar como barrera selectiva. A veces este tipo de antibióticos también afecta a las células de nuestro organismo.
También pueden desarrollar su acción por inhibir la síntesis de los ácidos nucleicos. Estas sustancias son imprescindibles para la síntesis de ADN. Por lo tanto, impiden la multiplicación de las bacterias.
Por último, pueden inhibir la síntesis de las proteínas. Las proteínas son las moléculas necesarias para la formación de estructuras. Por lo tanto son necesarias para la vida de las bacterias.
Cepas resistentes a antibióticos
Un gran problema que tenemos hoy en día en el ámbito de la salud es la resistencia a los antibióticos. Seguramente hayáis oído algo acerca de ello pero no lo tenéis del todo claro y no le dais la importancia que tiene.
Pues bien, que las cepas sean resistentes a antibióticos, quiere decir, básicamente, que este antibiótico ha dejado de ser eficaz contra esa bacteria, ¿y eso cómo puede pasar? Hay diversos mecanismos que desarrollan estos microorganismo para defenderse del efecto del fármaco.
Por otra parte podéis pensar que si ese fármaco ha dejado de ser eficaz frente a esa bacteria, podremos usar otro y se acaba el problema. Sí, es la solución que tenemos hoy en día, pero el problema reside en que abusamos del uso de los antibióticos y esas bacterias que están siendo tratadas con el otro antibiótico también pueden hacerse resistentes a él.
Por lo tanto, cada vez son menos los antibióticos que tenemos como arsenal contra las bacterias patógenas y podríamos quedarnos sin cura. El desarrollo de nuevos fármacos es un proceso complejo, largo y muy costoso.
Te recomendamos leer: El contagio de las bacterias entre parejas
Tipos de resistencias
La resistencia que presentan las bacterias puede ser de dos tipos:
Resistencia innata o natural
Este tipo de resistencia ya es conocida por los profesionales y saben que si se toma un determinado antibiótico no va ser eficaz frente a esa bacteria. Esto es debido a que el mecanismo de acción del fármaco afecta a algún elemento de la bacteria que no tiene.
Por ejemplo, las penicilinas afectan a la pared bacteria produciendo la muerte de la bacteria, pero hay bacterias que tienen unas enzimas, las β-lactamasas, capaces de neutralizar al fármaco y defendiéndose de su acción. Por lo tanto son resistencias intrínsecas al mecanismo de acción del antibióticos, preestablecida y conocida.
Resistencia adquirida
Este tipo de resistencia es desconocida, por lo tanto el médico o el profesional no se espera que el tratamiento no vaya a tener éxito. Se desarrollan debido a que la bacteria muta y adquiere genes de resistencia que la defienden del ataque de ese tratamiento.
Una vez que la bacteria muta y se transmite ese material genético de unas bacterias a otras haciendo que todas las especies de esa bacterias sean resistentes a ese fármaco.
Existen microorganismos multirresistentes, lo cuales son cepas resistentes a antibióticos diferentes a la vez, siendo esta característica también transferible a otras bacterias. Estas bacterias son muy peligrosas y se les conoce como “superbacterias“.
Por ejemplo, si padecemos una enfermedad provocada por una de estas bacterias, los antibióticos de elección para esta enfermedad pueden no valer para nada. Si la multirresistencia es amplia, puede que sea muy difícil curar esa enfermedad. Este es el problema al que los profesionales de éste ámbito se están enfrentando.
Es muy importante no automedicarse y no abusar de los antibióticos. Se deben tomar siempre con consentimiento del médico para evitar todos estos problemas.
Todas las fuentes citadas fueron revisadas a profundidad por nuestro equipo, para asegurar su calidad, confiabilidad, vigencia y validez. La bibliografía de este artículo fue considerada confiable y de precisión académica o científica.
- Alanis, A. J. (2005). Resistance to antibiotics: Are we in the post-antibiotic era? Archives of Medical Research. https://doi.org/10.1016/j.arcmed.2005.06.009
- Bhullar, K., Waglechner, N., Pawlowski, A., Koteva, K., Banks, E. D., Johnston, M. D., … Wright, G. D. (2012). Antibiotic resistance is prevalent in an isolated cave microbiome. PLoS ONE. https://doi.org/10.1371/journal.pone.0034953
- Rossolini, G. M., Arena, F., Pecile, P., & Pollini, S. (2014). Update on the antibiotic resistance crisis. Current Opinion in Pharmacology. https://doi.org/10.1016/j.coph.2014.09.006
- Kitaoka, M., Miyata, S. T., Unterweger, D., & Pukatzki, S. (2011). Antibiotic resistance mechanisms of Vibrio cholerae. Journal of Medical Microbiology. https://doi.org/10.1099/jmm.0.023051-0
Este texto se ofrece únicamente con propósitos informativos y no reemplaza la consulta con un profesional. Ante dudas, consulta a tu especialista.